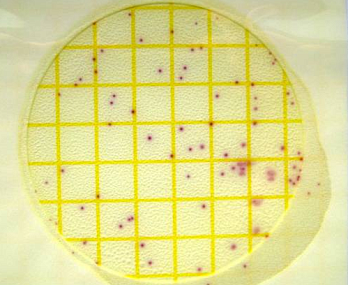

Экспресс-тест представляет собой пробирку с завинчивающейся крышкой и пластину с обеих сторон покрытую питательным агаром. В большинстве продуктов один из агаров используется для проведения неселективного общего подсчета. Другая поверхность с агаром позволяет идентифицировать другую группу микроорганизмов. Для применения необходимо окунуть пластинку в пробу на 5-10 секунд или прикоснуться платиной на короткое время к тестируемой поверхности затем закрутить её обратно в пробирку и поставить в тёмное прохладное место.
- С одной стороны пластины теста — среда для PCA;
- c другой стороны пластины теста — агар с глюкозой и фиолетовым красным.